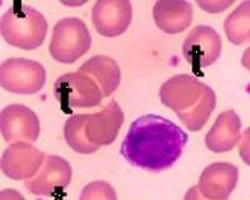
獲得性血友病

發病規律
AH的發病率每年約為0.2/100萬~1/100萬 可見於任何年齡段,但是,最多見於60~80歲老年人,其次為產後女性,兒童罕見。英國牛津血友病中心10年間收治的240例AH患者年齡為20~99歲,小於50歲的患者不到10%;Delgado等的報導中,AH患者年齡為8~93歲 男性105例(45%) 女性129例(55%),有2個年齡發病高峰段,即20~40歲和50~80歲。除青年段因女性妊娠使女性占多數外,在其他年齡段男女性別無顯著差異。
基本介紹
醫保疾病:否
患病比例:0.0001%-0.0003%
易感人群:無特殊人群
傳染方式:無傳染性
併發症:腦出血
就診科室:血液科 內科
治療方式:藥物治療 支持性治療
治療周期:終身治療
治癒率:無法根治,對症治療為主
病因
約50%的AH患者既往身體健康,無任何病因可查,另有50%的患者是繼發於其他疾病,與AH相關的最常見疾病是自身免疫性疾病,圍生期,惡性腫瘤,藥物反應(青黴素及其衍生物)和皮膚疾病,確認手術可能是AH的促發因素,Rizza等曾調查牛津血友病中心10年間收治的240例AH患者,結果發現98例有相關性疾病,其中惡性腫瘤24例,風濕性疾病16例,產後11例,Delgado等研究過去15年間Medline收錄的20篇有關AH的回顧性和前瞻性文章,總結234例患者的臨床特徵,發現與腫瘤相關的有43例(18%),與產後相關的有34例(15%),與自身免疫性疾病相關的有22例(9%),其他原因或未明確原因的有135例(58%)。
自身免疫性疾病(30%)
FⅧ自身抗體可見於多種自身免疫性疾病,抗體產生機制:全身自身免疫性疾病相關的炎性活動導致急性相反應蛋白被抗原提呈細胞提呈給免疫系統,導致自身抗體的產生,FⅧ就是這樣一種蛋白,可以部分解釋獲得性凝血因子抗體較常見於FⅧ而不是其他凝血因子,類風濕性關節炎患者的FⅧ自身抗體滴度通常較高,且不經治療或單用潑尼松治療不會降低,大多數患者需加用一種烷化劑以消除抗體。
產後免疫力低(15%)
常為初產婦,占2.5%~14%,表現為分娩後1~4個月內出血,也有產後1年才出血的報導,大多數患者體內自身抗體滴度較低,平均約為20 Bethesda單位(BU),如抗體滴度小於5BU,則抗體一般會自行消失,再次妊娠時不再出現,如滴度大於10BU,則抗體可持續數年,且對激素,靜脈注射丙種球蛋白製品,細胞毒藥物治療效差,該組患者的死亡率較低,為0~6%,抗體的出現機制可能是因為:①妊娠導致機體免疫狀態發生改變,來自胚胎的FⅧ通過胎盤滲漏至母體,被作為外來抗原導致母體產生FⅧ抗體,②自身免疫性疾病出現的前兆,③與胎盤分泌的因子有關。
惡性腫瘤(20%)
約占10%,見於實體瘤或血液腫瘤尤其是淋巴增殖性疾病包括慢性淋巴細胞白血病(CLL),紅白血病,骨髓纖維化,淋巴瘤,多發性骨髓瘤,骨髓增生異常綜合徵,Castleman病,抗體產生機制:T細胞對未知抗原或B細胞與T細胞間相互作用產生異常反應導致免疫功能失調,例如,CLL患者的白血病克隆或低度淋巴瘤患者的腫瘤性B細胞通過未知機制產生異常的FⅧ或抗原激發機體產生針對正常FⅧ的抗體反應,CLL患者CD5 的B細胞亞群擴增導致針對FⅧ的抗體產生增加,也有可能就是B細胞產生這些抗體,紅白血病患者則是白血病克隆導致T細胞和NK細胞功能調節失常,這些細胞,尤其是CD4 T細胞亞群在識別外來抗原,監視由B細胞產生的抗體方面起重要作用,免疫系統方面這些異常可解釋克隆性疾病,如紅白血病和骨髓纖維化,骨髓增生異常綜合徵中出現的針對FⅧ的自身抗體,AH與實體瘤的關係尚有爭論,有作者認為,實體瘤患者與是否有FⅧ抗體無因果關係,因為免疫抑制治療可消除大多數患者體內抗體,而手術切除腫瘤僅使得極少數患者體內抗體消失,治療腫瘤不能有效地清除抗體,免疫抑制治療的療效支持FⅧ自身抗體是機體對腫瘤的自身免疫反應這一假說,因為在老年人或腫瘤患者中,各種因素可以改變機體免疫狀態導致自身免疫性疾病的發生,免疫耐受減低導致病理克隆的增殖或自身抗體的產生,但是,也有作者認為,治療腫瘤可以清除抗體,如抗體持續存在,則是因為腫瘤處於晚期或轉移,是一種副癌綜合徵的表現,用免疫治療也無效。
藥物(15%)
如抗生素(青黴素,磺胺類藥,氯黴素)和抗驚厥藥(苯妥英鈉)與FⅧ自身抗體的關係已被確認,通常,這類抗體在高敏反應後出現,停藥後不久就消失,有報導CML者套用IFN-α治療後出現自身抗體,然而,此類現象的病理生理機制不清楚。
手術(10%)
手術導致FⅧ自身抗體產生的原因可能是:①與外傷,組織損傷有關,②伴隨手術的免疫功能失調,③對麻醉藥或其他藥物的反應。
預防
預防出血比替代治療更重要,包括:
(1) 加強宣教,避免劇烈活動,鼓勵適當體力活動。
(2) 避免使用抗血小板藥物。
(3)避免肌肉注射。
(4) 如需手術應在術前補充所缺乏的凝血因子。
(5) 有條件者應定期預防性補充相應凝血因子等。
(6) 血友病是許多有創操作的禁忌症,如拔牙、骨穿、外科手術等。在未給予凝血因子輸注干預前,避免盲目進行操作。
註:
可以進行妊娠後的產前診斷,進行優生優育。對血友病患者家人特別是女性患者,應做基因檢測。對於有家族史但無基因攜帶的女性,妊娠後可以放心的按正常程式分娩。而對於女性攜帶者,最好在妊娠後(一般12-14周內)做性別鑑定,若胎兒為女性,就可以按心做正常的足月分娩,如果胎兒為男性,則需要進行羊水穿刺等提取DNA檢測血友病的嚴重程度,或者通過臍帶血(大約在妊娠16-18周后)取樣以測定凝血因子的缺乏程度,根據實際情況確定是否進行治療性流產手術,特別是胎兒凝血因子嚴重缺乏的孕婦,應儘早終止妊娠。
併發症
血友病主要表面是出血,出血導致的併發症:
一、關節出血的併發症:關節損傷導致血友病性關節炎。
二、肌肉出血的併發症:輕者可以自然吸收,重者不能吸收會壓迫血管和神經,造成麻木和活動不利。
三、大腦出血的併發症:類似於中風。
檢查
1.激活的部分凝血活酶時間(APTT)
凝血酶原時間(PT)和血小板功能檢查 當APTT延長,PT和血小板功能正常時應考慮有無自身抗體存在,是檢查自身抗體的篩選試驗。
2.血漿混合試驗
當僅有APTT延長時,應進行血漿混合試驗測定APTT以確定抗體的存在,如APTT仍延長5s或以上為抗體存在,當內凝血途徑某一因子(FⅫ,FⅪ,FⅨ,FⅧ)缺乏時,正常血漿與患者血漿等量混合可糾正延長的APTT;但是,當有抗體存在時,等量血漿混合後延長的APTT,不能得到糾正,對於低滴度抗體,需將患者血漿與正常血漿在37℃共同孵育1~2h,以增強自身抗體對FⅧ的作用(以時間和溫度依賴的方式),因為高滴度的FⅧ自身抗體能非特異性地抑制內凝途徑中的凝血因子(FⅨ,FⅪ,FⅫ),所以需要把患者血漿系列稀釋並與未稀釋的正常血漿混合進行試驗,由於抗體被稀釋,FⅫ,FⅪ,FⅨ的活性正常,而FⅧ:C仍被抑制。
3.Bethesda試驗
一旦確定存在自身抗體,就應對抗體進行定量以評估出血的嚴重程度和危險性,常用的方法是Bethesda法,即檢測患者血漿滅活正常血漿中FⅧ的能力,一個Bethesda單位定義為檢測體系中剩餘FⅧ活性為50%時的患者血漿稀釋度,但是,該方法缺乏敏感性尤其是當抗體為低滴度時,此外,Bethesda法是為檢測在HA患者中出現的同種抗體而建立的,用於AH患者檢測自身抗體不是一個理想的方法,但是,用此法進行自身抗體的定量對低滴度自身抗體患者出血的嚴重性仍有預測作用。
4.改良Bethesda試驗
即將患者血漿與緩衝液稀釋後的正常人血漿共同溫育以保證體系pH值的恆定,同時將緩衝液稀釋後的正常人血漿與乏FⅧ血漿一起溫育作為對照,改良法提高了敏感性,尤其適合用於低滴度抗體的檢測,因此,被推薦為檢測抑制性抗體的首選方法,但是,與Bethesda法一樣,該法不能檢測非抑制性FⅧ抗體,所用的缺如FⅧ的血漿中不應有FⅧ抗體;同時對照和混合的血漿應是同一來源。
5.ELISA法
用重組FⅧ包被,4℃過夜,魚膠封閉非特異性位點,加入經稀釋的患者血漿並37℃孵育,再加入辣根過氧化物酶標記的兔抗人IgG,四甲基二氫氯化聯苯胺(TMB)作為發色底物,鹽酸終止反應,450nm處測吸光度(A),該方法能檢測所有抗FⅧ抗體,包括抑制性和非抑制性的自身抗體和同種抗體,其敏感性是Bethesda法的10倍,但是,該法在檢測時用作標準抗原的FⅧ來源對抗體檢出的敏感性有很大影響,用重組FⅧ做抗原時檢出率最高,用血漿來源的FⅧ因含高水平的血管性血友病因子(vWF),檢出率最低,所以臨床上在檢測FⅧ抗體時套用重組FⅧ做抗原。
6.免疫沉澱法(IP)
患者稀釋血漿與125I標記的FⅧ分子的A1,A2,C2,輕鏈片段共同孵育後,再加入蛋白G-sephrose結合的磁珠;用γ計數儀測定結合的放射活性,結果表示為免疫沉澱單位/ml,計算公式為:1-(結合放射活性/總放射活性一背景放射活性)×血漿稀釋倍數×16.7,該方法的敏感性和特異性與ELISA相同,也能檢測所有抗FⅧ抗體,包括抑制性和非抑制性的自身抗體和同種抗體,臨床上,在檢測FⅧ抗體時應同時進行Bethesda和ELISA法或IP法檢測。
7.FⅧ
C檢測 一期法不能判定FⅧ:C減低是因FⅧ自身抗體還是狼瘡抗凝物質引起,二期法則可鑑別,因在狼瘡抗凝物質存在時FⅧ:C水平正常或甚至增加;也可用血小板中和試驗或稀釋的RVVT來鑑別。
8.根據病情,臨床表現,症狀,體徵選擇做心電圖,B超,X線,CT,MRI,生化等檢查。
治療預後
獲得性血友病(一)治療
AH的治療包括止血治療和抗體清除。
1.出血的治療
AH患者出血的治療方案因無前瞻性研究難以評估各方案的優劣。一個重要的原則是要預防出血。微小的損傷、肌內注射、動脈內採血以及任何侵入性操作均應避免。阿司匹林或非類固醇抗炎藥也應避免套用。治療方案的確定取決於抗體滴度的高低和出血的嚴重程度。如果僅輕微出血且抗體滴度小於5BU,可套用1-去氨基-8-D-精氨酸加壓素(DDAVP)或輸注人FⅧ製品,如抗體滴度大於5BU,或輸注人FⅧ製品無效,可用激活的凝血酶原複合物(APCC)或凝血酶原複合物(PCC)或重組活化FⅦ(rFⅦa)製品或豬FⅧ製品。
(1)DDAVP:作用機制:提高FⅧ:C,內源性FⅧ的釋放可中和低滴度的自身抗體,也可能通過與微血管內皮細胞上的血管加壓素V2受體結合,導致cAMP增高,誘導vWF從內皮細胞中釋放,增加血漿vWF水平,抑制FⅧ與vWF結合封閉FⅧ自身抗體。劑量:0.3μg/kg,靜脈注射。DDAVP僅在一些抗體滴度小於3BU的患者中有效。
(2)人FⅧ製品:抗體滴度小於5BU的患者可用大劑量血漿純化的或重組人FⅧ製品。劑量:每個BU的抗體用重組人FⅧ20U/kg再另加40U。血漿FⅧ水平應在初始劑量後10~15min檢測,如未達到止血濃度(0.3~0.5U/ml),可重複使用一次。另一種方法是首劑200~300U/kg,續以4~14U/(kg·h)持續靜滴。因為輸注的人FⅧ很難完全封閉抗體,必須嚴密監測血漿FⅧ:C以調整人FⅧ製品劑量。
(3)豬FⅧ製品(Hyate-CR):作用機制:人FⅧ與豬FⅧ間的高度同源性使得豬FⅧ可在人體內起到止血作用,而人FⅧ自身抗體識別的關鍵表位與豬FⅧ上不同,使得輸注豬FⅧ製品後能夠獲得高水平的循環FⅧ。劑量:在自身抗體滴度小於50BU時,豬FⅧ製品套用劑量為50~100U/kg;抗體滴度50~100BU時,豬FⅧ製品劑量為100~200U/kg。平均劑量為90IU/kg,每12小時1次。治療效果為好和極好的占78%,部分有效和無效的分別占11%和9%。一項套用Hyate-CR治療64例AH患者的研究報導表明,止血效果極好和好的分別有26例和24例,療效一般或不好的僅有14例。主要不良反應是過敏反應和血小板減少,前者發生率為3%~7%且與劑量相關,後者輕微,是因為豬FⅧ內含有豬vWF且僅在1天內數次大劑量輸注豬FⅧ時才出現。這兩個不良反應均可以豬FⅧ持續輸注而減輕。另有研究報導,約有15%AH患者套用豬FⅧ製品後出現FⅧ自身抗體滴度增加。應嚴密監測血漿FⅧ:C和臨床治療效果以調整劑量。
(4)rFⅦa製品(NovoSevenR):為控制AH出血的主要方法。作用機制:超生理劑量的rFⅦa在損傷部位激活的血小板表面即使無FⅧ、FⅨ存在,也能通過活化FⅩ誘導凝血酶大量生成;在無FⅧ時克服FⅦ對凝血酶生成產生的抑制作用。劑量:90~120μg/kg,每2小時1次,可靜脈內注射或連續輸注,後者為一新的治療方式並可根據需要調整劑量。輕微出血僅需用藥2~3次,而大出血的治療需持續數天。無論是作為一線藥物還是二線藥物,rFⅦa製品治療AH患者的急性出血是安全、有效的。一項研究顯示38例AH患者中,88%的患者在治療後的8h或92%的患者在治療後24h顯示效果好或良好,24h內治療無效的患者繼續用rFⅦa製品治療也可能無效。另一項套用NovoSevenR的研究顯示,53例AH患者中93.9%的出血得到控制。其最大優點是不會傳播病毒,這對於AH患者來說是十分重要的,因為他們中的大多數從未接受過血製品,未來也可能不需用血製品。不良反應輕微:發熱、噁心。然而,使用rFⅦa製品必須謹慎,尤其是用於老年AH患者和伴有動脈粥樣硬化危險因素的患者。曾有1例HA伴有同種抗體的患者套用rFⅦa製品後出現急性心肌梗死的報導,雖然血栓形成可能是因為凝血機製得到改善的結果而不是rFⅦa本身的作用。另一缺點是該製品費用昂貴。需監測輸注後的PT和FⅧ:C來調整rFⅦa製品劑量。
當rFⅦa製品作為一線藥物無效時,可套用凝血酶原複合物(PCC)或激活的凝血酶原複合物(APCC)。
(5)APCC(FEIBAR或AutoplexR):主要成分為活化FⅨ(FⅨa)、活化FⅦ(FⅦa),以及少量FⅪa、FⅩa和凝血酶。輸入體內後,FⅩa和凝血酶被抗凝血酶迅速滅活,FⅪa和FⅨa產生額外的FⅦa,這可能是主要的活性成分。起始劑量為50~100U/kg,每8~12小時1次,每天最大劑量為200U/kg。在法國的一項套用FEIBAR的臨床試驗中,60例有FⅧ抗體的患者中6例為自身抗體,FEIBAR止血效果為81%,另一項套用AutoplexR的臨床試驗中,有13/17例患者獲得極其滿意的療效。不良反應是它可導致心肌梗死、靜脈血栓和彌散性血管內凝血(DIC)等血栓形成性疾病,已各有1例報導,有傳播病毒的危險,但是,尚未見有報導。實驗室檢測方法與臨床反應不相關,應根據臨床反應判斷療效和調整劑量。
(6)抗纖溶藥物:一個重要的治療措施是套用抗纖溶藥物,如氨基己酸(4~5g,口服,每4~6小時1次)或氨甲苯酸(25mg/kg,每8小時1次),作為輔助治療套用於AH患者口、鼻、局部傷口出血或月經過多的治療。抗纖溶治療可與上述除PCC和APCC外的藥物聯用,因為聯用後者有血栓形成的危險。
2.抗體的清除
可採用免疫調節療法以中和自身抗體或抑制、清除合成抗體的細胞克隆。
(1)靜脈注射人血丙種球蛋白(IVIg)製品:作用機制:主要是由於人血丙種球蛋白(IVIg)製品中存在抗個體基因型抗體,與自身抗體結合,抑制其活性,此外,人血丙種球蛋白(IVIg)製劑也抑制抗體合成。一項套用高劑量人血丙種球蛋白(IVIg)[1g/(kg·d)×2天或0.4g/(kg·d)×5天]治療AH的前瞻性研究提示,治療的有效率僅為25%~37.5%,與其他免疫抑制物合用時有效率為50%。該療法不良反應輕微,有頭痛、頭暈或瘙癢。但是,套用含高濃度蔗糖的人血丙種球蛋白(IVIg)製品偶可導致急性腎功能衰竭。人血丙種球蛋白(IVIg)製品不應作為AH患者的一線治療方案。
(2)血漿透析和免疫吸附:當必須迅速清除抗體尤其患者有嚴重出血時,可套用血漿透析和免疫吸附。已有數種血漿透析和體外免疫吸附法,如使用sepharose結合的葡萄球菌蛋白A、針對人重鏈和輕鏈的抗體、雙過濾血漿透析與免疫抑制療法聯合套用以清除FⅧ抗體。所有這些方法可替代血漿置換、減少病毒感染危險,尤其是對伴有高滴度抗體(>30BU)且對潑尼松龍治療無效或有危及生命的出血患者,聯合血漿透析和免疫抑制治療是一個有效方法。此外,重複的體外抗體免疫吸附治療而不同時進行免疫抑制治療也可有效降低FⅧ抗體水平、提高止血效果。但是,這些方法不能縮短至獲完全緩解的時間,應該與其他免疫抑制物聯用以獲得長期緩解和防止抗體再次出現。
(3)免疫抑制物:多種藥物可用來減少抗體合成,如潑尼松龍、環磷醯胺聯用或單用。潑尼松龍1mg/(kg·d)單用療效為30%,加用環磷醯胺1~2mg/(kg·d)後有效率達60%~100%,為多年來清除自身抗體的主要治療方法。一項有關潑尼松龍和環磷醯胺的隨機前瞻性研究已經完成。41例患者在用潑尼松龍1mg/kg, 3周后隨機分配,或繼以口服環磷醯胺2mg/kg或潑尼松龍加用環磷醯胺。39%的患者單用潑尼松龍有效,抗體消失。對激素無效的患者中,60%對環磷醯胺單用或與潑尼松龍聯用有效。對治療有效的患者其抗體滴度較低,但是,與無效者相比,在年齡、性別、相關疾病等方面無差異。另一項給以同樣劑量的研究中,7/9例患者抗體為高滴度(>5BU),結果所有患者在經過中位12周的治療後均獲完全緩解,停止治療後中位隨訪時間是91周。因此,對抗體滴度小於5BU的患者在嚴密觀察的情況下可單用潑尼松龍,高滴度抗體患者應聯合治療。
聯合套用潑尼松龍、環磷醯胺、長春新鹼或潑尼松龍、硫唑嘌呤治療AH也有效。但是,這種細胞毒方案有不良反應:中性粒細胞減少、繼發感染、脫髮、中毒性肝炎、骨髓增生異常。在決定是否對伴AH的腫瘤患者套用免疫抑制劑時應考慮如患者年齡、腫瘤類型、出血嚴重程度等一些其他因素。
環孢素也可用於AH患者治療。作用機制:抑制T細胞受體信號傳導中的關鍵酶calcineurin,抑制白介素轉錄、T細胞克隆擴增和產生細胞因子。1例慢性阻塞性肺病患者因AH套用潑尼松龍、環磷醯胺和人血丙種球蛋白(IVIg) 3個月後仍無療效,套用環孢素後,自身抗體滴度開始從40BU逐漸降低並最終消失,治療在8個月後停止。環孢素對機體造血功能無影響,較少引起感染併發症。提示環孢素可以套用於伴高滴度的AH患者。在其他治療措施無效時可考慮套用環孢素200~300mg/d,單用或與潑尼松龍合用。
Kain報導1例AH患者,最初對潑尼松龍、環磷醯胺治療有效,但是,在隨後的10年間先後對各種免疫抑制物,如潑尼松龍、環磷醯胺、硫唑嘌呤、環孢素和人血丙種球蛋白(IVIg)治療均失效,豬FⅧ製品、APCC、rFⅦa製品、氨甲苯酸等也無效。但是,連用利妥昔單抗(美羅華)375mg/m2,每周1次,連用4周后的4個月裡,抗體滴度從268BU降至1BU以下並得以維持,不再有嚴重的出血。
(4)口服FⅧ製品:有報導口服FⅧ製劑誘導免疫耐受以治療AH。一項試驗性研究中,3例患者給以FⅧ製品口服,1250U/d,連續3個月。1例患者APTT縮短,停止治療6個月後,FⅧ抗體滴度從228BU降至0.4BU以下,FⅧ:C從小於0.01U/ml升至0.17U/ml,與此同時,患者臨床症狀改善,出血次數減少。Nemes等採用FⅧ製品30U/(kg·d)第1周、20U/(kg·d)第2周、15U/(kg·d)第3周並聯合環磷醯胺、激素治療14例AH患者,結果13例患者體內抗體被清除。與既往比較,該方案誘導的免疫耐受出現時間早,而且沒有出血相關的死亡。但是,用FⅧ製品和其他藥物對AH患者進行免疫耐受誘導治療剛剛開始,需要進一步的研究以確定不同HA患者套用FⅧ製品誘導免疫耐受的可能性和適應證,以及治療方案的真正效果。
(二)預後
因為診斷延誤,AH患者較HA伴抗體的患者有更高的出血相關病死率,為7.9%~22%,其中有些死亡因素可能與自身抗體無關,死亡大多出現在疾病的前幾個周。Delgado等用薈萃(meta)法分析234例AH患者(年齡8~93歲,45%為男性)。結果發現3個因素對患者的總生存率(OS)有獨立的影響:即是否伴發相關疾病(惡性腫瘤、產後或其他疾病)、是否取得完全緩解(CR)、診斷時患者年齡(<65歲或>65歲)而且後兩個因素對疾病特異生存率(disease-specific survival,DSS)也有獨立的影響。抗體滴度對患者預後有很大影響,單因素分析表明,高滴度(>10BU)患者較低滴度(<10BU)患者有更好的OS和DSS,但是,多因素分析未提示此結論,與腫瘤相關的自身抗體的滴度較其他類型患者為低,其原因不清。獲完全緩解與較好的臨床結果顯著正相關。套用免疫治療的患者較未用者有較高的CR和較低的病死率,兩者間差異顯著。單個藥物分析提示環磷醯胺較潑尼松龍能更快地清除抗體,但是,接受環磷醯胺治療的患者有部分死於與藥物相關的併發症,主要為白細胞減少相關的感染。因妊娠導致的FⅧ自身抗體患者中絕大多數能自發緩解,長期預後良好,復發罕見。
護理
1、若關節腔出血,可抬高患肢,減少活動,給予冰袋冷敷止血,對反覆出血者應注意功能位置,出血停止後,腫痛消失,可適當活動,防止畸形。
2、告誡病人及家屬在生活中應儘量避免外傷,有出血傾向時要限制活動。
3、關節出血應完全休息,病人應臥床,患肢放於舒適的位置,對反覆出血者應注意功能位置。
4、臥床期間協助病人洗漱口、進食、大小便及個人衛生。
5、注意皮膚護理,防止皮膚受損,預防併發症發生。
飲食保健
具體飲食建議需要根據症狀諮詢醫生,合理膳食,保證營養全面而均衡,多吃蔬菜水果,飲食宜清淡,戒除菸酒,不要吃油膩、腥味、辛辣刺激性食物。